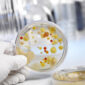
Bacterial DNA Barcoding Project: 16S rRNA Amplification Kit

Shop AP Bio
Goran Jakovljevic2026-03-29T05:41:49-04:00Use the filters to customize your AP Bio lab selections.
Showing 1 - 80 out of 80
Page 1 out of 1
| Thumbnails | Products | Price | Quantity | |
|---|---|---|---|---|
|
|
 |
Agricultural Monitoring Lab: A Case Study in Antibiotic Resistance
Antibiotic-resistant bacteria have been traced to one farm and neighbors are concerned. Use PCR to test soil samples from neighboring farms to determine if the antibiotic-resistant bacteria are present. |
$91.00
|
|
|
|
|
Bacterial DNA Barcoding Project: 16S rRNA Amplification Kit
Use PCR to amplify the 16S ribosomal RNA (rRNA) gene, a commonly used DNA barcode for bacterial identification. |
$128.00
|
|
|
|
 |
BioBits®: Antibiotic Resistance
Explore antibiotic resistance mechanisms - without culturing bacteria! Use a cell-free system to test antibiotics and a resistance gene with minimal equipment. |
$109.00
|
|
|
|
 |
BioBits®: Central Dogma (classroom kit)
Cell-free technology and fluorescent outputs allow students to directly visualize the flow of genetic information, from DNA to RNA to protein, all in real-time and with minimal preparation. |
$109.00
|
|
|
|
 |
BioBits®: Protein Structure and Function
Examine the primary, secondary, and tertiary structures of fluorescent proteins and predict their functions, then use a cell-free system to produce the proteins to test your predictions. |
$114.00
|
|
|
|
 |
Blue Egg Chicken DNA Test
Some chickens lay beautiful blue eggs, and this inherited trait follows an incomplete dominance pattern. This kit lets you use DNA testing to genotype your own chickens for the oocyan allele that causes blue eggs. |
$160.00
|
|
|
|
 |
Central Dogma Digital Lab
This Digital Lab introduces students to how living organisms decode the instructions contained in a DNA sequence, all in a virtual environment! |
|
|
|
|
 |
Central Dogma: BioBits® @home
Bring cutting-edge synthetic biology right into any learning setting! Using cell-free technology, you can visualize gene expression happening in real time right in front of your eyes. Our popular Central Dogma Lab, adapted for remote learning – everything you need is in this kit, even the hardware! |
$119.00
|
|
|
|
 |
Central Dogma: BioBits® @home (Set of 10)
Bring cutting-edge synthetic biology right into any learning setting! Using cell-free technology, you can visualize gene expression happening in real time right in front of your eyes. Our popular Central Dogma Lab, adapted for remote learning. Everything you need is in this kit – including hardware and reagents for 10 students, individually packaged! |
$1,115.00
|
|
|
|
 |
Chopped! Using CRISPR/Cas9 to cut DNA
Cut DNA in a test tube using the CRISPR/Cas9 system! |
$144.00
|
|
|
|
 |
Conservation Genetics Lab: Discovering Lemur Diversity
Scientists working in the forests of Madagascar may have rediscovered a species of lemur that was thought extinct. Analyze authentic field data and perform gel electrophoresis to make the call. |
$82.00
|
|
|
|
 |
COVID qPCR Lab: Detecting SARS-CoV-2 Infection
You work at an airport COVID-19 screening facility. Use low-cost tools to test patients for SARS-CoV-2 infection and get hands-on experience with the principles of qPCR diagnostics. |
$114.00
|
|
|
|
 |
Cystic Fibrosis Lab: Missy Baker Missing™
Missy Baker is missing! Use PCR to test whether DNA evidence collected from the cars of two different suspects matches Missy Baker. |
$91.00
|
|
|
|
 |
DNA Fingerprinting Lab: Shark Attack!
Shark attacks have been menacing Australian beachgoers. Use gel electrophoresis to compare DNA fingerprints from the shark attacks and determine if a single shark is to blame. |
$89.00
|
|
|
|
 |
DNA Glow Lab™: Exploring DNA Structure
Move beyond models and investigate DNA structure directly! Explore base pairing hands-on using a fluorescent dye to investigate the conditions that influence DNA structure and its transition from double helix to single strand, and vice versa. |
$91.00
|
|
|
|
 |
Dog Genetics Lab: Oodles of Labradoodles™
Molly the Labradoodle has surprised you with a litter of puppies! In this lab, students use gel electrophoresis to track the inheritance of a single trait, and use their findings to determine the most likely father of Molly’s puppies. |
$82.00
|
|
|
|
 |
Dye Electrophoresis Lab: Cat Genetics
A purr-fect introduction to genetics. Track inheritance in a family of cats using Punnett squares. Then, use gel electrophoresis to examine how genetic differences control that trait. Connect Mendelian genetics with our modern understanding of genes! |
$71.00
|
|
|
|
|
Dye Electrophoresis Lab: Mendel's Peas
Some of Mendel’s peas have been discovered in an old notebook! Use gel electrophoresis to confirm which gene Mendel was studying in the 1800s. This lab connects Mendel’s famous experiments with our modern understanding of DNA and inheritance. |
$71.00
|
|
|
|
 |
Dye Electrophoresis Lab: Microbe Hunters
Astronauts aboard the International Space Station (ISS) need your help protecting themselves from disease-causing bacteria! Students use molecular techniques to identify the bacteria growing aboard the ISS. |
$71.00
|
|
|
|
 |
Dye Electrophoresis Lab: Molecular Rainbow
Analyze dye samples using gel electrophoresis. |
$67.00
|
|
|
|
 |
Dye Electrophoresis Lab: Princes in the Tower
Explore a historical mystery with forensic DNA analysis! In 1483, two English princes vanished, and now their remains might have been found. Use gel electrophoresis to carry out forensic DNA analysis on the unidentified remains. |
$71.00
|
|
|
|
 |
eDNA Project: Sampling Soil for Antibiotic Resistance
Use PCR and gel electrophoresis to help monitor the spread of antibiotic resistance in the environment. In the process engage directly with one of the great health challenges of our time! |
$142.00
|
|
|
|
 |
eDNA Project: Sampling Soil for Antibiotic Resistance (Refill Kit)
Use PCR and gel electrophoresis to help monitor the spread of antibiotic resistance in the environment. In the process engage directly with one of the great health challenges of our time! |
$99.00
|
|
|
|
 |
Electrophoresis Forensics Lab: Wrongfully Convicted?
J.M. was convicted of a crime and is currently incarcerated but has always maintained his innocence. Students will use gel electrophoresis to analyze DNA samples from J.M.’s case to see if the new DNA evidence supports the original conviction. |
$71.00
|
|
|
|
 |
Food Safety Lab: Food Truck Trouble!
Investigate a public health emergency at a food truck festival using molecular biology tools! Use PCR, restriction digestion, and gel electrophoresis to track pathogenic E. coli to its source. |
$91.00
|
|
|
|
 |
Forensics Lab: Analysis of the D1S80 VNTR
A crime has occurred in your classroom! Use PCR to compare your DNA to the crime scene evidence to prove your innocence. |
$91.00
|
|
|
|
 |
Fungal DNA Sequencing Add-On
Reagents and tubes to facilitate submission of ITS samples for Sanger sequencing. (Sequencing not included.) |
$53.00
|
|
|
|
 |
Galápagos Penguin Lab: Biodiversity at Risk
Galápagos penguins have faced multiple population declines due to El Niño events. Students use gel electrophoresis to compare the genetic diversity of different penguin species and link their findings to differences in ecology and extinction risk. |
$82.00
|
|
|
|
 |
Glowing Gradients: Exploring Fluorescence Through Serial Dilution
Practice serial dilution with fun, fluorescent reagents, then estimate the concentration of unknown samples. |
$56.00
|
|
|
|
 |
GMO Detection Lab
Fast and robust PCR-based GMO detection from your favorite foods. Engage in a real-world biotechnology application relevant to agriculture, environmental science, and the food industry. |
$91.00
|
|
|
|
 |
Hemophilia Genetics Lab: X-linked Inheritance
Baby Andrew has been diagnosed with hemophilia. Use gel electrophoresis to determine whether his female relatives carry the same X-linked mutation. |
$71.00
|
|
|
|
 |
Inherited Cancer Risk Lab: Lynch Syndrome
Discover how genetic testing can diagnose hereditary cancer risk. Students will analyze gel electrophoresis results to diagnose members of a fictional family and track inheritance through pedigrees. |
$71.00
|
|
|
|
 |
Knockout! A CRISPR/Cas Gene Targeting Lab
Perform cutting-edge genome editing! This lab allows students to use CRISPR/Cas to disrupt a gene in bacteria and observe the resulting phenotypic change. Updated 2025 protocol: half the prep, 5-10 times better results! |
$238.00
|
|
|
|
 |
Knockout! A CRISPR/Cas Gene Targeting Lab (Refill kit)
Refill kit for CRISPR/Cas Knockout! Lab including cells and transformation reagents but no plasticware or solid media. Updated 2025 protocol: half the prep, 5-10 times better results! |
$199.00
|
|
|
|
 |
Knockout! PCR Genotyping Experiment
Optional follow-up: Confirm gene knockout at the molecular level. |
$89.00
|
|
|
|
 |
Lambda DNA Restriction Digestion Analysis
Students analyze DNA fragment patterns produced by restriction enzyme digestion of Lambda phage DNA. They will compare single and double digests to determine the cutting sites and estimate fragment sizes using a DNA ladder. |
$92.00
|
|
|
|
 |
Lavender Chicken DNA Test
Lavender chickens have attractive pale greyish plumage that is said to shimmer, and this inherited trait follows a recessive pattern. This kit lets you use DNA testing to determine if your chickens carry the lavender allele. |
$160.00
|
|
|
|
 |
$37.00
|
|
|
|
|
 |
Lyophilized E. coli for Knockout! Lab
Optional add-on to carry out transformations on different days. Note: This product is only sold as a companion to Knockout! A CRISPR/Cas Gene Targeting Lab (KT-1800-01), and it is not sold separately. |
$39.00
|
|
|
|
 |
Microbe Hunters Digital Lab - FREE
Students use molecular techniques to identify the bacteria growing aboard the International Space Station, all in a virtual environment!
Access this FREE Digital Activity by clicking on this link. |
|
|
|
|
 |
Microbiology Plate Pouring Kit
Materials to prepare LB agar plates for bacterial culture. |
$37.00
|
|
|
|
 |
Micropipette Art Cards, Set of 8
A classroom's worth of supplies to introduce and practice micropipetting in a fun and engaging way. Follow our art patterns or create your own microliter masterpiece! |
$13.00
|
|
|
|
 |
Micropipette Art: Full STEAM Ahead!
A classroom's worth of supplies to introduce and practice micropipetting in a fun and engaging way. Follow our art patterns or create your own microliter masterpiece! |
$63.00
|
|
|
|
 |
Micropipetting @home: Microliter Madness
Micropipettes allow scientists to accurately measure small volumes of liquid. Gain proficiency in this critical lab skill through three engaging activities:
|
$37.00
|
|
|
|
 |
Micropipetting @home: Microliter Madness (Set of 10)
Micropipettes allow scientists to accurately measure small volumes of liquid. Gain proficiency in this critical lab skill through three engaging activities:
|
$325.00
|
|
|
|
 |
Micropipetting 101
Micropipettes allow scientists to measure small volumes of liquid accurately. Hone your micropipetting skills by practicing with reusable supplies. |
$63.00
|
|
|
|
 |
Micropipetting Practice Cards, Set of 20
20 Reusable Micropipetting Practice Cards. |
$23.00
|
|
|
|
 |
Micropipetting Practice Dyes
Three micropipetting practice dyes: Blue, Yellow, and Red (5 ml each). |
$16.00
|
|
|
|
|
miniPCR Digital Add-On Pack
Add 10 students to a Digital Lab Pass or All-Access Pass on miniPCR Digital. |
$5.00
|
|
|
|
|
miniPCR Digital All-Access Pass
Assign unlimited Digital Labs to one class of up to 40 students on miniPCR Digital. |
$40.00
|
|
|
|
|
miniPCR Digital All-Access Pass Upgrade
Upgrade your single-activity Digital Lab Pass to an unlimited All-Access Pass on miniPCR Digital. |
$15.00
|
|
|
|
|
miniPCR Digital Lab Pass
Assign one Digital Lab to one class of up to 40 students on miniPCR Digital. |
$25.00
|
|
|
|
 |
miniPCR Sleep Lab™: Lark or Owl?
Participate in an authentic investigation on the genetics of sleep and circadian clocks. Use PCR and gel electrophoresis to determine your own genotype at a locus that has been associated with morning vs. evening preference. |
$91.00
|
|
|
|
 |
Mushroom ID Project: Fungal DNA Barcoding Kit
PCR amplify the ITS region, a fungal DNA barcode that you can sequence and match to genetic databases for molecular identification of fungi. |
$102.00
|
|
|
|
 |
P51™ @home: STEM Explorations That GLOW!
Fluorescence is a tool used widely in the sciences and beyond. But it is also a fascinating phenomenon in its own right. Use the handheld P51™ fluorescence viewer to explore the world of fluorescence right at home! |
$53.00
|
|
|
|
 |
P51™ @home: STEM Explorations That GLOW! (Refill kit)
Fluorescence is a tool used widely in the sciences and beyond. But it is also a fascinating phenomenon in its own right. Use the handheld P51™ fluorescence viewer to explore the world of fluorescence right at home! (Refill kit) |
$19.00
|
|
|
|
 |
P51™ @home: STEM Explorations That GLOW! (Set of 10)
Fluorescence is a tool used widely in the sciences and beyond. But it is also a fascinating phenomenon in its own right. Use the handheld P51™ fluorescence viewer to explore the world of fluorescence right at home, with this set of 10 kits ready for remote learning. |
$509.00
|
|
|
|
 |
P51™ Chlorophyll Lab: A Free Resource
Separate plant pigments using paper chromatography and investigate whether the different pigments will fluoresce when suspended in a solvent. Chlorophyll will fluoresce red! This is a free download, no materials are shipped. |
$0.00
|
|
|
|
 |
P51™ Enzyme Lab: β-Gal Glow™
Conduct five inquiry investigations of enzyme activity. Measure the effect of pH, temperature, concentration, and competitive inhibition on reaction rates. |
$112.00
|
|
|
|
 |
P51™ Molecular Fluorescence Viewer
Visualize DNA, RNA, and proteins at work right in the palm of your hand. |
$35.00
|
|
|
|
 |
P51™ Molecular Fluorescence Viewer - Classroom Set of 8
Visualize DNA, RNA, and proteins with this classroom set of 8. |
$250.00
|
|
|
|
 |
P51™ qPCR Lab: Principles of Quantitative PCR
Explore qPCR using your existing PCR machine! Directly visualize DNA amplification and calculate relative concentrations of DNA template. |
$114.00
|
|
|
|
 |
Plant Genetics Lab: Taking Mendel Molecular with Wisconsin Fast Plants®
Investigate the genotypic basis of a phenotype using Wisconsin Fast Plants®. Link stem color phenotypes to their underlying genotypes using PCR to differentiate between alleles of a gene responsible for plant pigmentation. |
$91.00
|
|
|
|
 |
Plasmid DNA Restriction Mapping Lab
Introduce students to the use of restriction enzymes for creating plasmid maps. This activity uses pre-digested plasmid DNA samples ready for gel electrophoresis and can be completed in a single class period! |
$71.00
|
|
|
|
 |
Protein Expression and Purification Lab
Express a mix of fluorescent proteins and watch as you purify them - with magnets! Using cell-free technology and magnetic beads, this classroom-friendly lab gives students hands-on experience with the essential biotech protein expression and purification methods. |
$123.00
|
|
|
|
 |
PTC Taster Digital Lab
This Digital Lab introduces students to the molecular techniques of PCR, restriction digestion, and gel electrophoresis, all in a virtual environment! |
|
|
|
|
 |
PTC Taster Lab Control Bands
Pre-digested PTC Taster control bands to help interpret student genotypes. |
$41.00
|
|
|
|
 |
PTC Taster Lab: Genotype to Phenotype
Examine how genetic variations affect our ability to perceive the world around us. Use molecular techniques to determine whether you carry taster or non-taster alleles. |
$91.00
|
|
|
|
 |
Recessive White Chicken DNA Test
Not all white chickens are the same; white plumage can result from different genetic mutations. This kit lets you use DNA testing to genotype your own chickens for the recessive white allele. |
$160.00
|
|
|
|
 |
Shark Lab: Great White Migration
Scientists have spotted similar-looking shark fins in four very different locations–are white sharks migrating across oceans? Students use DNA fingerprinting to explore shark ecology in this engaging gel electrophoresis activity. |
$71.00
|
|
|
|
 |
Sickle Cell Genetics Digital Lab
Students use PCR, restriction digestion, and gel electrophoresis to test a family for the sickle cell allele, all in a virtual environment! |
|
|
|
|
 |
Sickle Cell Genetics Lab: Diagnosing Baby Marie™
ALL NEW CURRICULUM! Will baby Marie be affected by sickle cell disease? Use gel electrophoresis to analyze her family's DNA for the sickle cell allele. |
$71.00
|
|
|
|
|
Silicone Practice Gels, set of 10
Set of 10 durable, reusable silicone practice gels. |
$38.00
|
|
|
|
 |
True Blue Digital Lab
Run a complete bacterial transformation experiment in a virtual environment—no equipment required! |
|
|
|
|
 |
True Blue™ Transformation Lab: Genetically Engineering Bacteria
Conduct a bacterial transformation experiment in a single 45 minute class period! This lab enables students to genetically engineer bacteria and observe the resulting blue phenotype. |
$119.00
|
|
|
|
 |
Viral Diagnostics Lab: Beating the Next Pandemic
A new virus is spreading across the globe. Use gel electrophoresis to determine if patients complaining of viral symptoms have seasonal flu or are infected with the new virus. |
$71.00
|
|
|
|
 |
ZeeWee™ I Bird DNA Sex Test: Chickens
Use DNA testing to identify the sex of your own chickens! Birds have Z and W sex chromosomes. In this activity, use PCR to determine if your chickens are male (ZZ) or female (ZW). |
$160.00
|
|
|
|
 |
ZeeWee™ II Bird DNA Sex Test: Parrots
Use DNA testing to identify the sex of your own parrots! Birds have Z and W sex chromosomes. In this activity, use PCR to determine if your parrots are male (ZZ) or female (ZW). |
$160.00
|
|
|
|
 |
ZeeWee™ III Bird DNA Sex Test: Fowl
Use DNA testing to identify the sex of your own fowl! Birds have Z and W sex chromosomes. In this activity, use PCR to determine if your fowl are male (ZZ) or female (ZW). |
$160.00
|
|
|
|
 |
ZeeWee™ IV Bird DNA Sex Test: Emus
Use DNA testing to identify the sex of your own emus! Birds have Z and W sex chromosomes. In this activity, use PCR to determine if your emus are male (ZZ) or female (ZW). |
$160.00
|
|